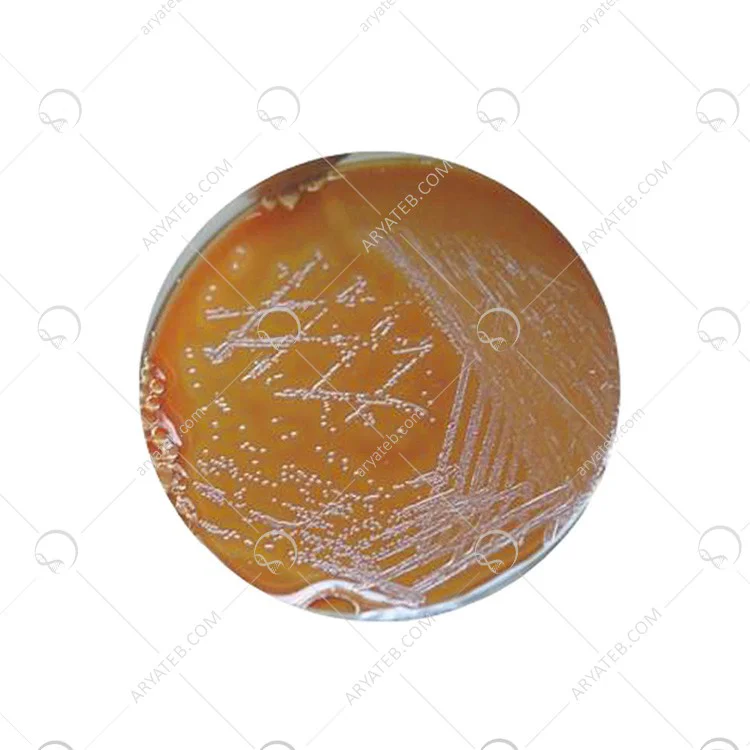

آگار GC Agar
تماس بگیرید
با توجه به نوسانات قیمت محصولات لطفا قبل از ثبت سفارش با کارشناسان آریاطب تماس بگیرید
تماس بگیرید
قیمت ویژه همکاران
اکانت شما ویژه همکاران نمی باشد
محیط کشت آگار GC Agar
نظر خود را ارسال کنید
آدرس ایمیل شما منتشر نخواهد شد. فیلدهای الزامی علامت گذاری شده اند *
قیمت ویژه همکاران
اکانت شما ویژه همکاران نمی باشد
اطلاع از موجودی